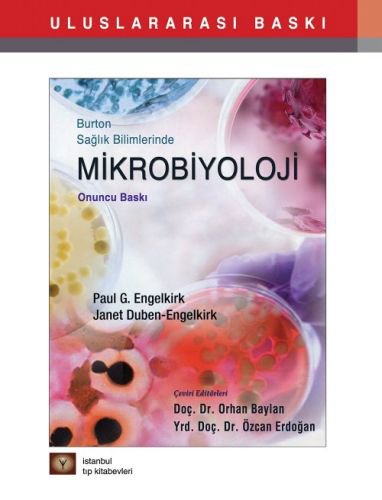
product

Burton Sağlık Bilimlerinde Mikrobiyoloji
2.090,00 TL
| SKU | 9786054949830 |
|---|---|
| Yazar | Paul G.Engelkirk,Janet Duben-Engelkirk |
| Çevirmen | Orhan Baylan - Özcan Erdoğan |
| Yayınevi | İstanbul Tıp Kitabevi |
| Basım Yılı | 2016 |
| Sayfa Sayısı | 482 |
| Kapak Türü | Karton Kapak |
| Baskı Sayısı | 10. Baskı |